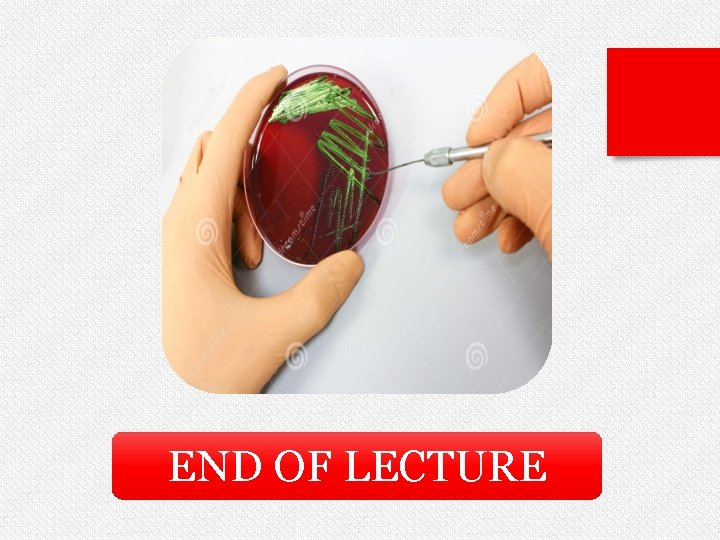
END OF LECTURE

Media Multiple Tests v Several media are designed

- Slides: 27
Media & Multiple Tests v. Several media are designed to yield more than one biochemical reaction. Among the more commonly used media in this category are: 1) SIM medium. 2) Kliger's Iron agar (KIA). 3) Triple Sugar Iron agar (TSIA). 4) Lysine Iron agar (LIA). 5) Motility Indole Ornithine (MIO) medium.
IM Medium v. SIM Test Medium is a semisolid medium used as differential test medium. § { S } “sulfide”, discriminates organisms that can take up sodium thiosulfate, they can reduce it to sulfite using the enzyme thiosulfate reductase, with the release of hydrogen sulfide gas. § { I } “indole”, discriminates organisms that can produce tryptophanase to hydrolyze the amino acid tryptophan into indole, ammonia and pyruvic acid. § { M } “motility” discriminates motility (presence of flagella), ability to “swim” through media production.
INGREDIENTS § § 0. 4% agar ( semisolid). Peptone ( which rich in treptophan amino acid ). Sodium thiosulfate Ferrous ammonium sulfate. H 2 S Indicator The ingredients in SIM Medium enable the determination of three activities by which enteric bacteria can be differentiated. 1) Sodium thiosulfate and ferrous ammonium sulfate for indication of hydrogen sulfide production. The ferrous ammonium sulfate reacts with H 2 S gas to produce ferrous sulfide, a black precipitate. 2) The peptone is rich in tryptophan, which is attacked by certain microorganisms resulting in the production of indole. The indole is detected by the addition of Kovac’s reagent.
3) Motility detection is possible due to the semisolid nature of the medium growth radiating out from the central stab line indicates that the test organism is motile. v The ability to reduce sulfur is specific to two members of the enteric family: Salmonella and Proteus and aids in distinguishing them from other enterics. § Salmonella (H 2 S positive and motile), § Proteus (H 2 S positive and motile), § Klebsiella (nonmotile and does not produce H 2 S).
Procedure : 1) Label each of the SIM agar deep tubes with the name of the bacterium to be inoculated, your name, and date. 2) Using aseptic technique inoculate each tube with the appropriate bacterium by stabbing the medium of the way to the bottom of the tube. Do the same for the three motility test medium deeps. 3) Incubate the cultures for 24 to 48 hours at 35°C. Note : If Bacteria can produce hydrogen sulfide , we can not detect the motility of organism. Unfortunately, the motility aspect of this test typically gives false negative results.
Indole negative (kovac's reagent did not turn red) and hydrogen sulfide negative (agar did not turn black).
If indole is produced from the breakdown of the amino acid tryptophan, the Kovac's reagent, when added, will turn red. Indole negative (Kovac's reagent did not turn red) and hydrogen sulfide positive (agar turned black)
Kligler's Iron agar (KIA)& Triple Sugar Iron agar (TSI) KIA and TSIA are widely used in the identification of gram negative bacteria particularly the Enterobacteriaceae. The media are identical except that TSI contains sucrose in addition to the dextrose and lactose found in KIA. The media are poured as slants and are inoculated with a stab to the butt followed by a streak of the slant surface. The bacteria therefore are exposed to both an anaerobic environment (butt) and an aerobic one (slant). Phenol red is present as an indicator. Do not tighten the cap on the tube. If the bacteria are non-fermenters, such as Pseudomonas, they can grow on the slant by the aerobic degradation of protein components in the medium.
v. INGREDIENTS § Enzymatic Digest of Casein. § Enzymatic Digest of Animal Tissue. § Yeast Enriched Peptone. § Dextrose. . 0. 1 %. § Lactose. . . 1. 0 %. § Sucrose. . . 1. 0 %. Not present in Kligler's Iron Agar. § Ferric Ammonium Citrate. As H 2 S Indicator H 2 S. § Sodium Chloride. § Sodium Thiosulfate. § Phenol Red. As p. H Indicator. § Agar. . . . 1. 5 %. § Final p. H: 7. 4 ± 0. 2 at 25°C.
§Enzymatic Digest of Casein, Enzymatic Digest of Animal Tissue, and Yeast Enriched Peptone provide the nitrogen, carbon, and vitamins required for organism growth. § Triple Sugar Iron Agar contains three carbohydrates, Dextrose, Lactose and Sucrose. When the carbohydrates are fermented, acid production is detected by the Phenol Red p. H indicator. § Sodium Thiosulfate is reduced to hydrogen sulfide, and hydrogen sulfide reacts with an iron salt yielding the typical black iron sulfide. § Ferric Ammonium Citrate is the hydrogen sulfide (H 2 S) indicator. § Sodium Chloride maintains the osmotic balance of the medium. § Agar is the solidifying agent.
v SIGNIFICANCE: This test is of a great value in the initial identification of the family Enterobacteriaceae. v TSIA detects three primary characteristics of a bacterium: 1) The ability to produce gas from the fermentation of sugars, 2) The ability ferment lactose and sucrose 3) The production of large amounts of hydrogen sulfide.
v. PRINCIPLE: For fermentative organisms, glucose is the first sugar catabolized. If glucose is used up, a bacterium reaches a metabolic fork in the road. If an organism produces the enzymes to hydrolyze the disaccharide lactose, the organism will continue fermenting to assist in ATP generation. However, if the glucose is limiting and the organism does not produce the necessary enzymes to catabolize lactose, the organism can utilize the protein in the medium via the process of deamination.
Procedure : 1) Inoculate the test organism on TSIA slants by stabbing the butt and streaking the slant completely. 2) Incubate for 24 hours at 37 o. C. Note : Timing is critical in reading KIA/TSIA results. An early reading could reveal yellow throughout the medium, leading one to conclude that the organism is a lactose fermenter when it simply may not yet have exhausted the glucose. A reading after the lactose has been depleted could reveal a yellow butt and red slant leading one to falsely conclude that the organism is a glucose only fermenter.
RESULTS From left to right: Morganella morganii (K/A, atypically not producing gas), Pseudomonas aeruginosa (K/NC), uninoculated control, Proteus mirabilis(K/A, H 2 S), and Escherichia coli (A/A, G).
Lysine Iron Agar (LIA) v. INGREDIENTS § Yeast Extract. § Dextrose. . 0. 1 %. § L-Lysine. . 1. 0 %. § Enzymatic Digest of Gelatin. § Ferric Ammonium Citrate. As H 2 S Indicator § Sodium Thiosulfate. § Bromocresol Purple. As p. H Indicator § Agar…………. . . 1. 5 %. § Final p. H: 6. 7 ± 0. 2 at 25°C.
v. LIA agar is used to determine whether a Gramnegative rod decarboxylates or deaminates Lysine and forms Hydrogen sulfide (H 2 S). v Lysine deamination is an aerobic process which occurs on the slant of the media. Lysine decarboxylation is an anaerobic process which occurs in the butt of the media. Salmonella: Alkaline/alkaline/H 2 S Citrobacter: Alkaline/yellow/H 2 S
Procedure : 1) LIA is slanted when made and is inoculated by streaking the slant and stabbing the butt and slant. 2) Incubate at 35◦C ± 2◦C for 18 to 24 h. Results:
Motility Indole Ornithine (MIO) Medium v. INGREDIENTS § Yeast Extract. § Peptone. § L-Ornithine……. . 0. 5%. § Dextrose. . . 0. 1%. § Agar ……………. 0. 4%. § Bromcresol Purple. As p. H indicator § Final p. H 6. 5 ± 0. 2 at 25°C.
v. PRINCIPLE: MIO Medium is prepared to provides three differentiating tests in one culture tube: motility, Indole production, and ornithine decarboxylation. The principles of each are outlined below: § MOTILITY: Organisms are stabbed into the semisolid medium using a straight wire. ü If the organisms are motile, they will migrate from the stab line by means of their flagella, producing turbidity or cloudiness throughout the medium. ü Non-motile organisms grow only along the stab line, leaving the surrounding medium clear.
§ORNITHINE: The medium also tests for the presence of the enzyme ornithine decarboxylase by including L-ornithine in the agar. üIf the organism possesses the enzyme, it will be activated in an acid environment created by the initial fermentation of glucose. Once the amino acid is decarboxylated, the byproduct diamine putrescine is produced. The result is a shift in p. H to the alkaline range, turning the medium a dark purple. üOrganisms, which do not possess the enzyme, will stay in the acid range due to the fermentation, resulting in a yellow color in the medium.
§ INDOLE: Tryptophan is an ingredient contained in the medium by the inclusion of peptones. üA Positive test results: red color will form at the top of the medium, If the organism possesses the enzyme tryptophanase, with the addition of Kovacs reagent. üA negative test results: no color change.
END OF LECTURE